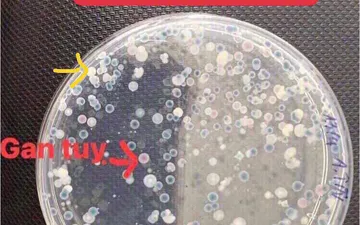
CÁCH KIỂM TRA MẬT SỐ VIBRIO TRONG NƯỚC VÀ TÔM
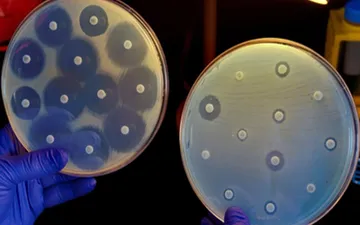
CÁCH LÀM KHÁNG SINH ĐỒ TẠI AO

ẢNH HƯỞNG CỦA CHẾ ĐỘ CHO ĂN KHÁNG THỂ LÊN KHẢ NĂNG ĐỀ KHÁNG BỆNH TRÊN TÔM
Khi tôm bị nhiễm khuẩn việc điều trị bằng kháng sinh trở nên phổ biến. Việc sử dụng kháng sinh không đúng qui định gây ảnh hưởng tới sức khỏe động vật nuôi, môi trường sinh thái, tạo ra các chủng vi khuẩn kháng thuốc kháng sinh dẫn đến giảm hiệu quả điều trị bệnh, tăng nguy cơ nhiễm khuẩn và tồn lưu trong sản phẩm thủy sản. Do vậy việc sử dụng kháng thể giúp tăng cường miễn dịch kháng lại các bệnh nguy hiểm trên tôm đã được thực hiện và mang lại hiệu quả cao.
Globulin miễn dịch (Immunoglobulins – Ig) là kháng thể có bản chất glycoprotein. Globulin miễn dịch (Immunoglobulins Y - IgY) được tạo ra từ lòng đỏ trứng gà và có sự khác biệt về bản chất protein so với Ig của động vật hữu nhũ. IgY là kháng thể đặc trưng của nhóm động vật lông vũ và do đó IgY có thể được sản xuất với lượng lớn trong lòng đỏ trứng gà (Muller et al., 2015). Để tạo ra kháng thể đặc hiệu, kháng nguyên đặc hiệu (Vibrio parahaemolyticus, Vibrio harveyi, Vibrio anguillarum) được tiêm vào cơ ức của gà mái. Kháng thể đặc hiệu sau khi được tạo ra sẽ chuyển sang lòng đỏ trứng của trứng gà con để tạo ra kháng thể IgY. IgY đã được áp dụng thành công trong các lĩnh vực nghiên cứu về chẩn đoán, phòng ngừa, điều trị… do sự ổn định của việc sản xuất IgY (Xu et al., 2011).
Với hiệu quả và tiềm năng sử dụng của IgY trong phòng bệnh, việc nghiên cứu “Ảnh hưởng của kháng thể lòng đỏ trứng gà đến khả năng đề kháng bệnh hoại tử gan tụy cấp tính của tôm thẻ chân trắng (Penaeus vannamei)” đã được thực hiện nhằm tìm ra giải pháp hữu hiệu giúp phòng bệnh cho tôm nuôi.
THÍ NGHIỆM CẢM NHIỄM
Tôm được xác định không nhiễm virus WSSV và V. parahaemolyticus (0,43 g/tôm) và được cho ăn thức ăn có bổ sung kháng thể IgYA và IgYB (ADBIOTECH Co., LTD, Hàn Quốc) trong thời gian 5 tuần, bao gồm: nghiệm thức đối chứng không bổ sung IgY, nghiệm thức bổ sung IgYA 0,5%, nghiệm thức bổ sung IgYB 0,5%.
Sau đó được cảm nhiễm với vi khuẩn V. parahaemolyticus bằng phương pháp ngâm với nồng độ đã được xác định cho phép gây chết tôm với tỉ lệ 50% (mật độ 1,6 x 107 CFU/mL) (Tran et al., 2013). Tôm sau khi cảm nhiễm tiếp tục được bổ sung IgYA 0,5% và IgYB 0,5% tương ứng với theo từng nghiệm thức và cho ăn theo nhu cầu.
Tôm được theo dõi ghi nhận dấu hiệu bệnh lý và tỉ lệ chết trong vòng 14 ngày. Tôm thẻ chân trắng sau 3 ngày cảm nhiễm được thu với số lượng 9 tôm/nghiệm thức để phân tích các chỉ tiêu huyết học và hoạt tính PO. Tôm có dấu hiệu lờ đờ được phân lập vi khuẩn từ mẫu gan tụy và định danh vi khuẩn bằng phương pháp PCR.
KẾT QUẢ CẢM NHIỄM
Kết quả thí nghiệm cho thấy tôm ở nghiệm thức đối chứng âm (NT1) không bổ sung IgY và không cảm nhiễm với vi khuẩn V. parahaemolyticus có tỉ lệ chết là 1,11% cho đến khi kết thúc thí nghiệm, khác biệt có ý nghĩa thống kê so với các nghiệm thức còn lại (p<0.05). Tôm ở nghiệm thức này hoạt động bình thường, gan tụy sẫm màu và ruột đầy thức ăn.
Ở các nghiệm thức tôm cảm nhiễm với V. parahaemolyticus (NT2 không bổ sung IgY, NT3 bổ sung IgYA 0,5%, NT4 bổ sung IgYB 0,5%) xuất hiện tôm chết ở ngày thứ 1 sau khi cảm nhiễm và ngưng chết ở các ngày thứ 5, 6, 7 lần lượt ở NT4, NT3, NT2. Khi kết thúc thí nghiệm, tỉ lệ chết tích lũy của tôm ở NT2 (đối chứng dương) là 52,22%, tiếp theo là NT3 (bổ sung IgYA 0,5%) có tỉ lệ chết tích lũy là 45,56% và khác biệt có ý nghĩa thống kê (p<0.05) so với NT4 (bổ sung IgYB 0,5%) có tỉ lệ chết 21,11%. NT4 (bổ sung IgYB 0,5%) có tỉ lệ chết tích lũy thấp nhất trong các nghiệm thức cảm nhiễm với vi khuẩn V. parahaemolyticus và khác biệt có ý nghĩa thống kê so với các nghiệm thức còn lại (p<0.05).
Ngoài ra, trong ngày thứ 2, 3 sau khi cảm nhiễm ở nghiệm thức không bổ sung IgY (NT2) có số lượng tôm chết nhiều hơn so với các nghiệm thức còn lại và kéo dài cho đến ngày thứ 7. Trong khi đó, tôm ở các nghiệm thức bổ sung IgY và cảm nhiễm với vi khuẩn thì có số lượng tôm chết ít và thời gian chết ngắn hơn (Hình 1).
Các chữ cái (a, b, c) khác nhau trên đồ thị thể hiện sự khác biệt có ý nghĩa thống kê (p < 0,05)
Giếng M: thang DNA 100 bp; Giếng (-): đối chứng âm; Giếng (+): đối chứng dương; Giếng 1: mẫu của nghiệm thức đối chứng không bổ sung IgY cảm nhiễm với V. parahaemolyticus; Giếng 2-3: mẫu của các nghiệm thức 3,4 bổ sung IgY và cảm nhiễm với V. parahaemolyticus.
Kết quả thí nghiệm trên cho thấy bổ sung IgY vào thức ăn có khả năng giúp tôm tăng cường sức đề kháng với vi khuẩn gây bệnh hoại tử gan tụy cấp tính V. parahaemolyticus, trong đó tôm ở nghiệm thức bổ sung IgYB 0,5% có tỉ lệ chết thấp nhất trong suốt thời gian cảm nhiễm. Thí nghiệm này tương đồng với kết quả nghiên cứu của Gao et al. (2016). Tôm thẻ chân trắng ở các giai đoạn zoea, mysis và postlarvae được cho ăn bổ sung 1,5% IgY có chứa kháng thể kháng đặc hiệu V. harveyi và V. parahaemolyticus trong một tuần. Kết quả ghi nhận tôm đề kháng được với tác nhân gây bệnh với tỉ lệ chết tích lũy lần lượt là 37,3% (zoea), 39,3% (mysis), 38,0% (postlarva) sau 48 giờ cảm nhiễm với V. harveyi so với nhóm tôm đối chứng có tỉ lệ chết tích lũy tương ứng là 84,0%, 84,7%, 88,0% (p<0.05). Nhóm tôm cảm nhiễm với V. parahaemolyticus có tỉ lệ chết tích lũy lần lượt là 40,0% (zoea), 41,4% (mysis) và 43,3% (postlarva) so với tỉ lệ chết tích lũy của tôm nhóm đối chứng là 86,7%, 84,0% và 87,3% (p<0.05). Qua đó cho thấy hiệu quả bảo vệ của IgY giúp vật chủ kháng lại các tác nhân gây bệnh.
Ảnh hưởng của việc bổ sung kháng thể lòng đỏ trứng gà lên sự đáp ứng miễn dịch của tôm thẻ chân trắng (Penaeus vannamei) sau khi cảm nhiễm với V. parahaemolyticus
Mẫu máu tôm được thu ở thời điểm 3 ngày sau cảm nhiễm để phân tích các chỉ tiêu miễn dịch bao gồm tổng tế bào máu, bạch cầu có hạt, bạch cầu không hạt và hoạt tính PO. Kết quả phân tích được trình bày ở Bảng 1.
Kết quả tổng tế bào máu của tôm được trình bày ở Bảng 1 cho thấy NT1 tôm không bổ sung IgY và không cảm nhiễm với V. parahaemolyticus có tổng tế bào máu là 1,46x104 tb/mm3 khác biệt có ý nghĩa thống kê so với các nghiệm thức còn lại (p<0,05) so với NT1 là 0,21x104 tb/mm3 và NT3 là 0,20x104 tb/mm3 (Bảng 1). Hoạt tính PO được trình bày qua Bảng 1 ghi nhận: sau 3 ngày cảm nhiễm, hoạt tính PO có sự khác biệt có ý nghĩa thống kê (p<0.05). Trong khi đó, tổng tế bào máu ở các nghiệm thức cảm nhiễm với V. parahaemolyticus, NT4 (bổ sung IgYB 0,5%) có giá trị THC cao nhất (1,89x104 tb/mm3 ) và khác biệt có ý nghĩa thống kê (p<0.05) so với NT2 (không bổ sung IgY) 1,05 x104 tb/mm3 và NT3 (bổ sung IgYA 0,5%) là 1,02x104 tb/mm3.
Khảo sát sự biến động số lượng từng loại bạch cầu, chỉ tiêu bạch cầu không hạt (hyaline cells - HC) ở NT4 gia tăng đáng kể, có giá trị cao nhất với 1,53x104 tb/mm3 khác biệt có ý nghĩa thống kê (p0,05) so với NT1 là 0,21x104 tb/mm3 và NT3 là 0,20x104 tb/mm3 (Bảng 1). Hoạt tính PO được trình bày qua Bảng 1 ghi nhận: sau 3 ngày cảm nhiễm, hoạt tính PO có sự khác biệt có ý nghĩa thống kê (p<0.05) so với các nghiệm thức còn lại.
Trong thí nghiệm này, kết quả phân tích các chỉ tiêu miễn dịch của tôm thẻ chân trắng sau khi cảm nhiễm cho thấy chế độ bổ sung IgYB 0,5% giúp gia tăng đáp ứng miễn dịch của tôm, thông qua sự gia tăng số lượng tế bào máu, bạch cầu có hạt, bạch cầu không hạt và hoạt tính PO giúp tôm gia tăng sức đề kháng, tăng tỉ lệ sống khi cảm nhiễm với V. parahaemolyticus.
Việc sử dụng kháng thể lòng đỏ trứng gà đã tạo ra giải pháp hữu hiệu giúp phòng bệnh hoại tử gan tụy cấp tính cho tôm nuôi.
Kháng thể được sản xuất tại ADBIOTECH - Hàn Quốc và đang được công ty XNK Nguyên Liệu Topline phân phối tại thị trường VN. Quý khách cần thông tin chi tiết về kháng thể vui lòng liên hệ số hotline 0983 69 15 15 để được hỗ trợ!
Chúc quý bà con vụ mùa bội thu!